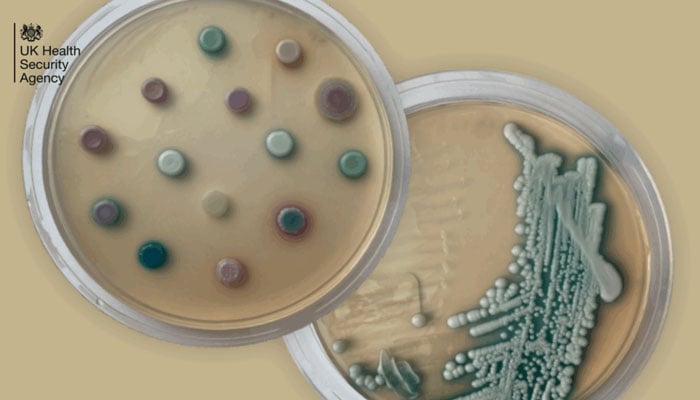

-
فرمان الہی
-
نماز کے اوقات
- جمعرات 6؍ شوال المکرم 1447ھ26؍مارچ 2026ء
- بانی: میرخلیل الرحمٰن
- گروپ چیف ایگزیکٹووایڈیٹرانچیف: میر شکیل الرحمٰن

 فرمان الہی
فرمان الہی
 نماز کے اوقات
نماز کے اوقات

انگلینڈ میں ایک نئے قسم کے انفیکشن سے مریضوں کی بڑی تعداد کے اسپتال پہنچنے کا انکشاف ہوا ہے۔
یو کے ہیلتھ سیکیورٹی ایجنسی نے اس امر کی تصدیق کی ہے کہ نئے انفیکشن جو (Candidozyma) کی ایک قسم مانی جارہی ہے کے منفی اثرات سے مریض اسپتالوں میں داخل ہو رہے ہیں۔
مذکورہ وائرس جلدی سطحی سے انسانی جسم میں داخل ہوتا ہے اور خون کی روانی کو متاثر کرتا ہے۔ یہ انفیکشن کئی برس تک کسی بھی انسان کے جسم میں زندہ رہنے کی بھی صلاحیت رکھتا ہے۔
2009 میں پہلی مرتبہ جاپان میں اس وائرس کا انکشاف ہوا تھا جبکہ ابتک دنیا کے 40 سے زائد ممالک اس سے متاثر ہو چکے ہیں۔
یو کے ہیلتھ سیکیورٹی ایجنسی کے ذمہ داران کا کہنا ہے کہ جلد پر کسی بھی قسم کے آپریشن، دوران زخم یا فنگس کے ذریعے جسم میں داخل ہونیوالا مذکورہ وائرس بعض صورتوں میں انسان کیلئے زیادہ خطرناک ہو سکتا ہے۔
اس انفیکشن کے بڑی تعداد میں مریضوں کے اسپتالوں میں ٹیسٹ کیے جاتے ہیں بنیادی طور پر یہ چھونے سے بھی پھیلنے کی صلاحیت رکھتا ہے۔